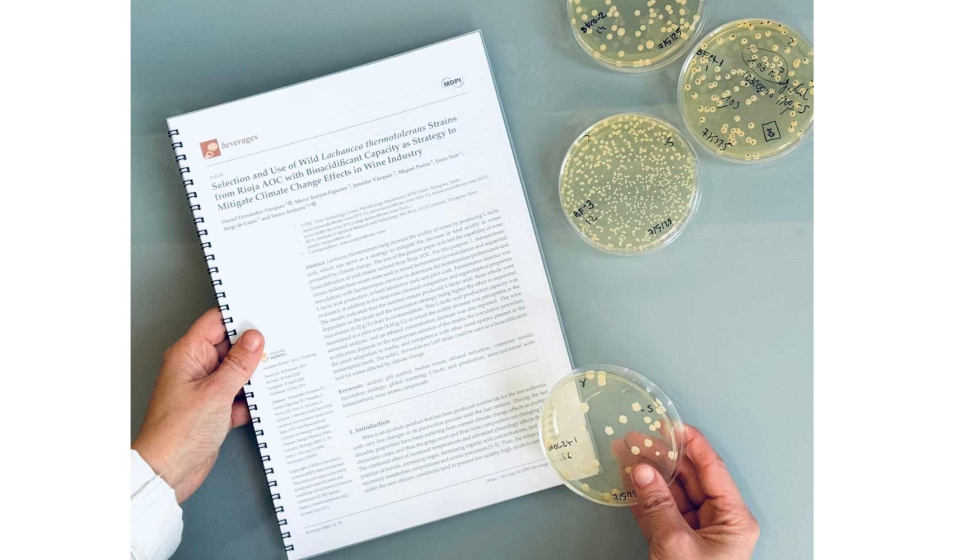
Imagen

Vitec publica un nuevo estudio sobre la acidificación natural de los vinos como respuesta al cambio climático
El Centro Tecnológico del Vino (Vitec) continúa impulsando la investigación de soluciones naturales para contrarrestar los efectos del cambio climático en la viticultura. Recientemente, un equipo de investigadores de Vitec ha publicado un nuevo trabajo científico en la revista Beverages en que se analiza el potencial de troncos salvajes de la levadura Lachancea thermotolerans, aisladas de mostos de una bodega de la DOQ Rioja, para incrementar la acidez de los vinos mediante la producción de ácido láctico.
El objetivo del estudio ha estado evaluar la capacidad de estas quitados para acidificar el vino de forma natural en diferentes condiciones de fermentación, tanto a pequeña escala como en pruebas piloto. Se han medido los ritmos de fermentación, la composición final de los vinos y sus características sensoriales.
Los resultados han demostrado que los troncos de L. thermotolerans aisladas pueden generar cantidades destacadas de ácido láctico, contribuyendo a mejorar la acidez total del vino, una calidad clave para equilibrar vinos elaborados en condiciones de temperatura más elevadas.
Esta investigación evidencia que la acidificación biológica natural mediante levaduras no convencionales como L. thermotolerans puede ser una herramienta eficaz para adaptar la elaboración de vinos a los nuevos escenarios climáticos, siempre que se seleccionen correctamente los troncos y se defina la estrategia de aplicación más adecuada.
El estudio ha sido realizado por los investigadores de Vitec Daniel Fernández Vázquez, la dra. Mercè Sunyer Figueres, el doctpr Miquel Puxeu Vaqué, Enric Nart Comas, Sergi de Lamo Castellví y la doctora Imma Andorrà Solsona, con la colaboración de la dra. Jennifer Vázquez González.












